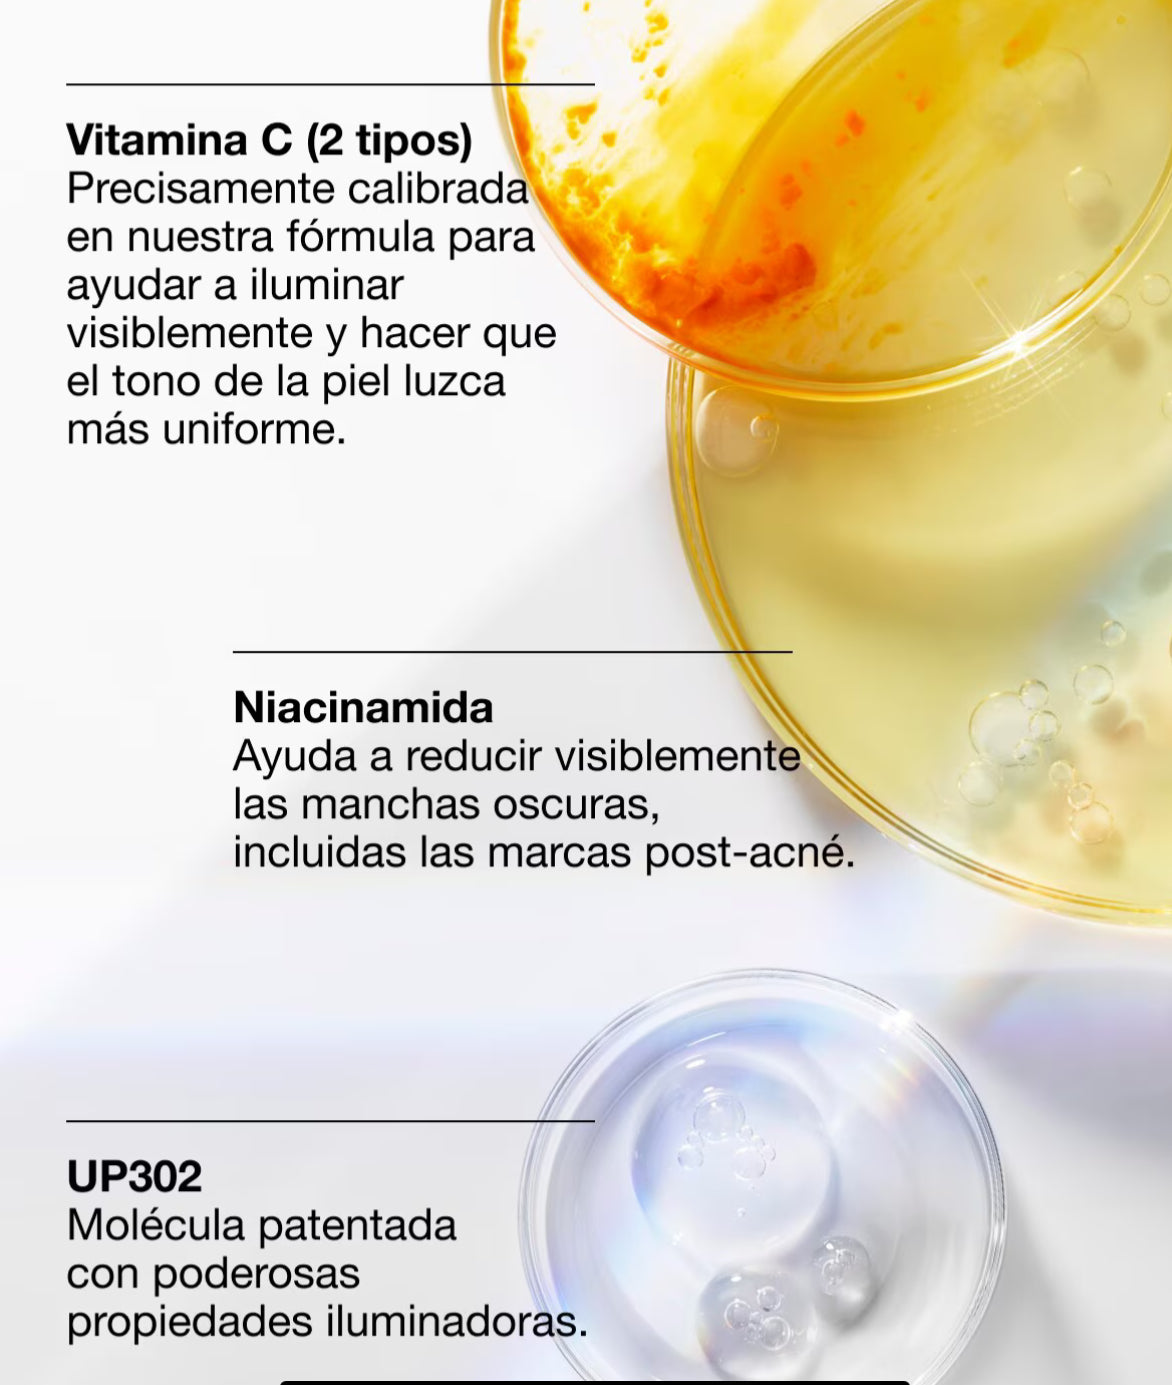

TiendaCindylu
SERUM EVEN BETTER CLINICAL 50ML - CLINIQUE
SERUM EVEN BETTER CLINICAL 50ML - CLINIQUE
El suero iluminador más avanzado de Clinique, diseñado para tratar la hiperpigmentación. Su fórmula avanzada, que incluye niacinamida y vitamina C, ofrece evidentes resultados de iluminación reduciendo visiblemente las manchas oscuras y marcas posteriores a los brotes.
Reduce visiblemente las manchas oscuras, incluidas las manchas solares, manchas de la edad y marcas posteriores a los brotes. Esta fórmula mejorada proporciona una exfoliación a nivel superficial y rompe el aspecto de la hiperpigmentación, como las manchas oscuras y el tono desigual. La piel se ve más luminosa y uniforme. Los ingredientes calmantes ayudan a calmar la piel, al reducir visiblemente la irritación que podría provocar futuras manchas oscuras.
Libre de:
- Sometido a pruebas de alergias.
- 100% libre de fragancia.
- Desarrollado por dermatólogos.
- Probado por dermatólogos.
- Probado por oftalmólogos.
- Libre de aceite.
- Libre de alcohol secante.
- Libre de colorantes sintéticos
Tipo de piel:
- Todo tipo de piel
Precio habitual
$99.990 CLP
Precio habitual
Precio de oferta
$99.990 CLP
Precio unitario
por
Impuesto incluido.
No se pudo cargar la disponibilidad de retiro